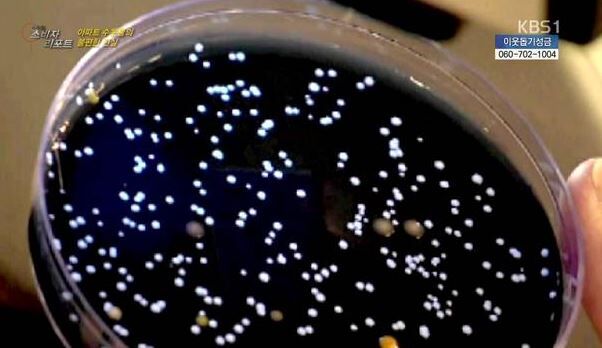
4

https://twitter.com/TIOffoa1lny67Ii/status/1277555140921180160 午後7:50 · 2020年6月29日 小咲なな @TIOffoa1lny67Ii これが韓国が世界に誇る新技術✨ K増し増し再生! なんと一人の人間が幾つものデバイスを駆使して、ひたすら同じ動画を再生。そして「再生回数を見よ!これが世界のトレンド!」と勝ち誇る恐るべき技術です! https://twitter.com/Mp92G1/status/1276866187813502976 午後10:13 · 2020年6月27日 なんテディベア2つのハート @Mp92G1 堂々と不正して楽しいん? ほんまに理解できない。 #outkpop https://twitter.com/AMATlls/status/1117552351802298368?ref_src=twsrc%5Etfw%7Ctwcamp%5Etweetembed%7Ctwterm%5E1117552351802298368&ref_url=https%3A%2F%2Fsnjpn.net%2Farchives%2F124655 午前7:16 · 2019年4月15日 btsファンがうっかり再生数増やしの舞台裏を暴露 https://twitter.com/tsuisoku/status/1276237174686363648 午前4:33 · 2020年6月26日 韓国 防弾少年団、新曲が公開から約37時間で再生回数1億回を突破!世界最短記録! ファンが再生数上げ工作の現場をツイートしてしまうww http://tsuisoku.com/archives/55163661.html 2019年04月15日 防弾少年団、新曲「Boy With Luv」が公開から約37時間で再生回数1億回を突破!世界最短記録を更新 kstyle https://news.kstyle.com/article.ksn?articleNo=2115111 2019年04月14日14時41分 BTS(防弾少年団)、新曲「Boy With Luv」が公開から約37時間で再生回数1億回を突破!世界最短記録を更新 必死で工作・・ https://twitter.com/peachy_joonie_/st...

コメント
コメントを投稿